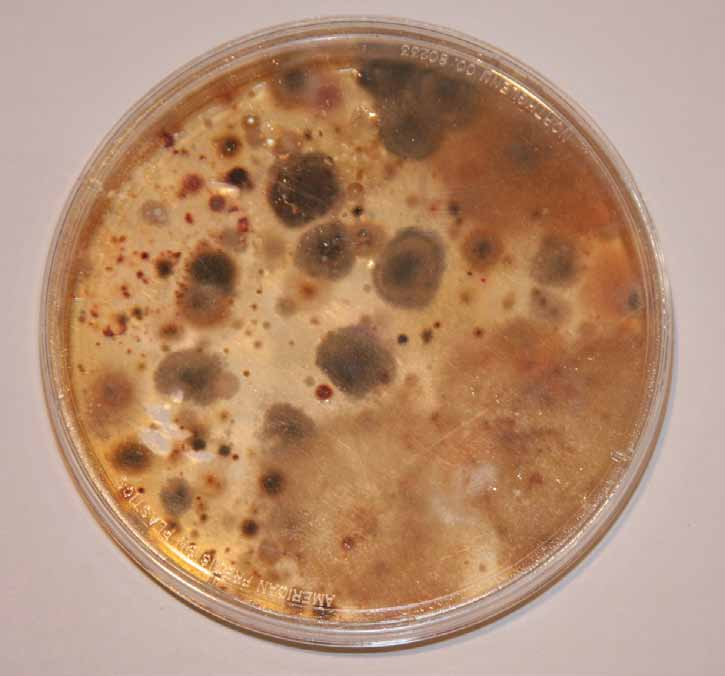
Petri Dish Comparison

Our Air machines have been used and tested for decades in many rough environments, with A+ passing grades – Earth, Space, FDA Certified Class II Medical Device, CDC, DoD and many more. The Air technology is how plants were grown in Space.
AIR MACHINES
FDA Class II Medical Device Approval
FDA2020 FDA Clearance Letter - Official FDA Class II Medical Device approval documentation.
View DocumentNASA-Based Technology® Rapidly Reduces 99.9% of Airborne SARS-CoV-2 Virus
NASA

FDA-Compliant Military Lab Tests - NASA-Based Technology (2020)
View DocumentActive Peer-Reviewed Study
ResearchAmerican Journal of Infection Control - Published research on ActivePure Technology effectiveness
View StudyKansas State Testing Results
Testing
Bacteria and Fungi Testing Charts from Kansas State University
View DocumentKansas State Testing Results (Online)
TestingComprehensive testing data from Kansas State University
View DocumentResults for Inactivation of L. Pneumonia
ResearchTest results for Legionella pneumophila inactivation
View DocumentAmerican Journal of Infection Control, HAIs
Research

Healthcare-Associated Infections study published in peer-reviewed journal
View DocumentEPA Requires Schools to Improve Indoor Air Quality
EPAEPA guidelines for school indoor air quality requirements
View Guidelines